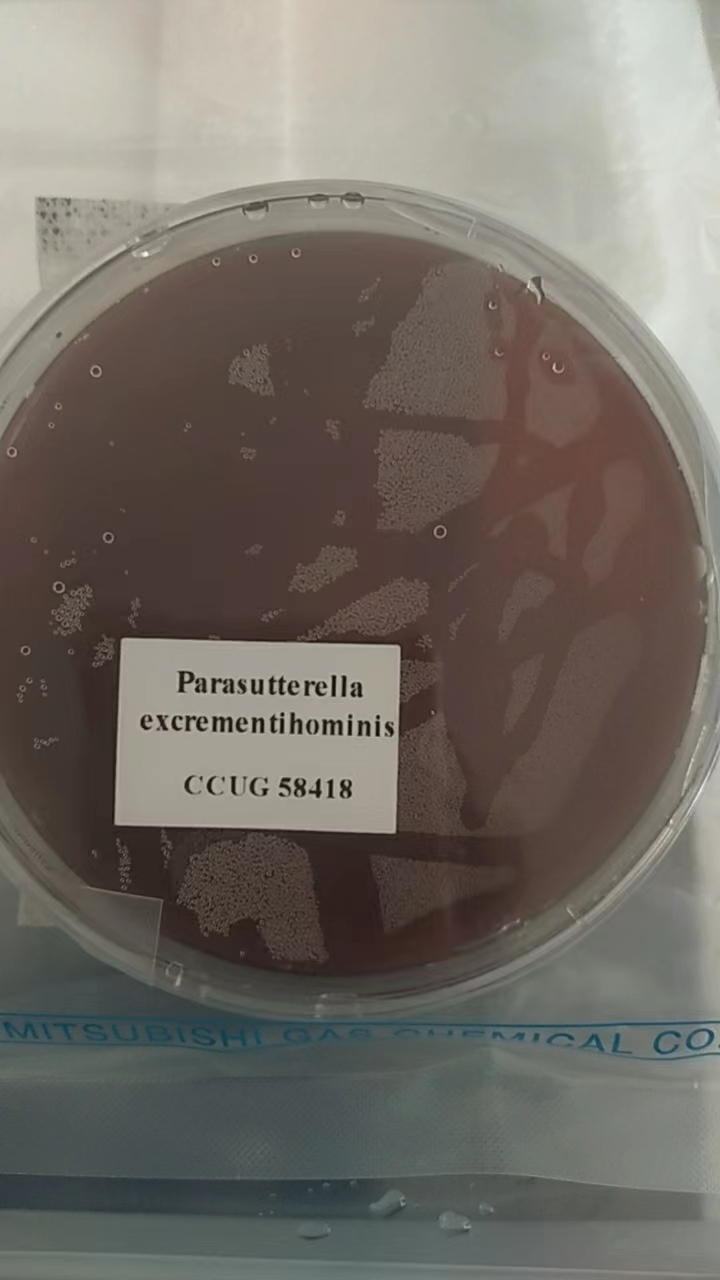

当前位置: 首页
>菌株▍最近浏览历史
- CCGU58418
货号: - 结肠平滑肌细胞
货号:BRCC-d011 - 甲状腺成纤维细胞
货号:BRCC-g002 - 蜡样芽孢杆菌显色培养基(第三代)
货号:HB7021-2
▍更多产品
- 货号:ATCC 10231
名称:ATCC10231白色念珠菌
- 货号:ATCC 29212
名称:ATCC 29212粪肠球菌
- 货号:CICC 24634
名称:CICC 24634
- 货号:
名称:人诱导多能干细胞(iPSC)培养体系
- 货号:
名称:CCGU58418
▍联系我们
-
欢迎访问中国微生物菌种细胞网,本站隶属于北京博瑞康沐生物技术有限公司,官方网址:www.brccbio.org.cn,单位现提供微生物菌种及其细胞等相关产品查询、咨询、订购、售后服务!与国内外多家研制单位,生物医药,第三方检测机构,科研院所有着良好稳定的长期合作关系!
-
联系方式:
-
-
冯经理 : 18811029336 (微信同号)
-
刘经理 : 13671235527 (微信同号)
-
王经理 : 18613852577 (微信同号)
-
陈经理 : 18811029296 (微信同号)
-
免费电话:400-616-3123
-